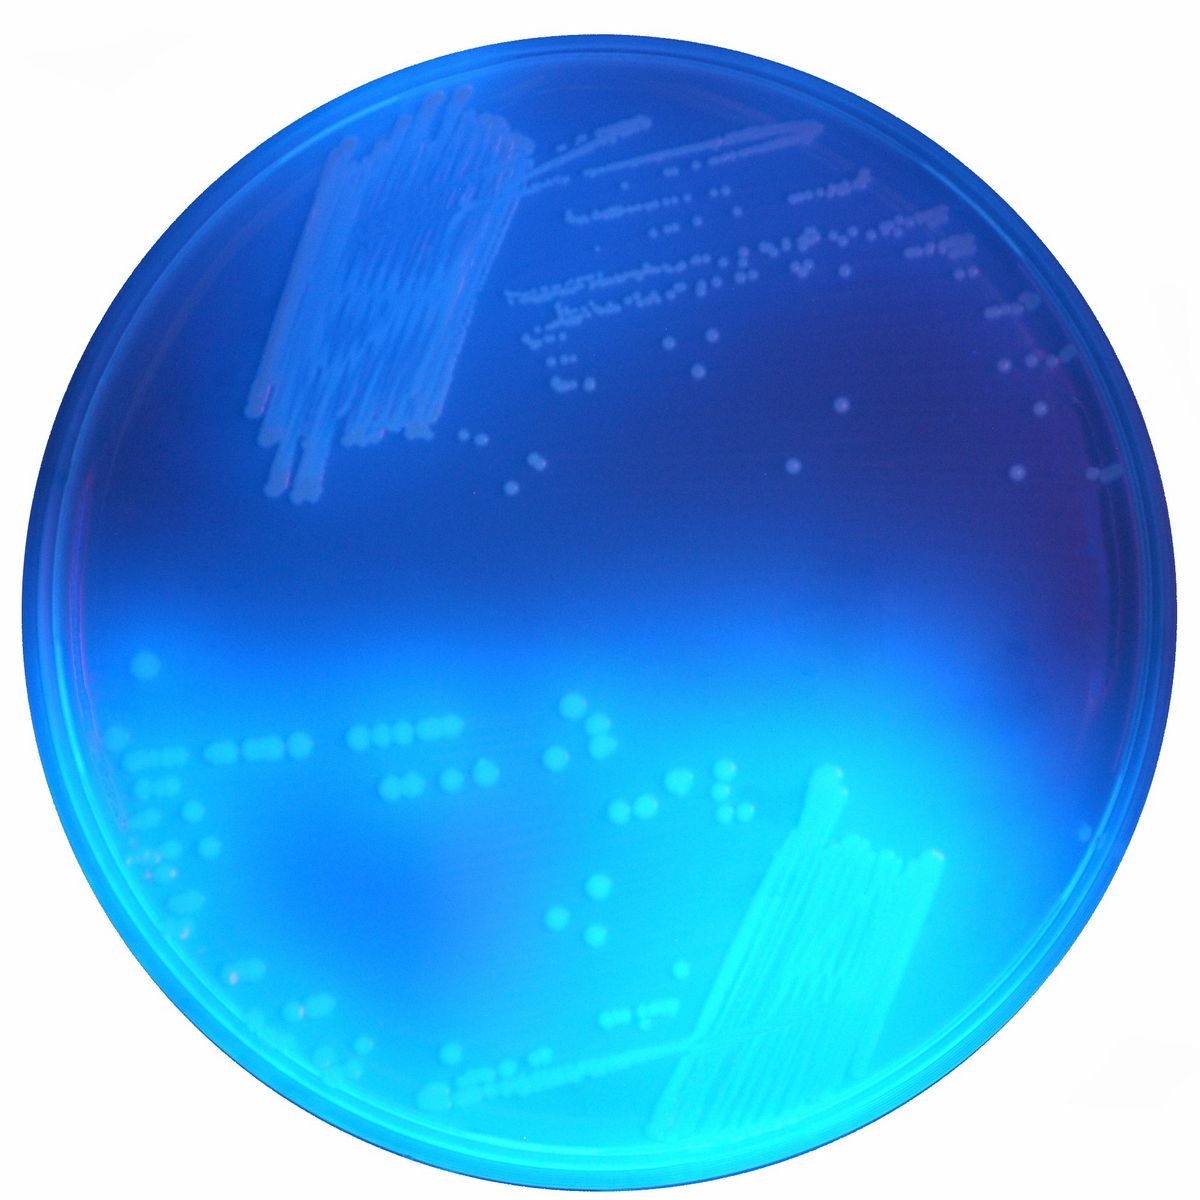
CHROMagar™ C. difficile - 5000 ml

C03-109-500 g
A solid medium employed for the isolation of Clostridium difficile
Package size: 500 g
Enquire for price
DKK 3.000,00
Not in stock, delivery 1-2 weeks
Fluorogenic medium for detection of Clostridium difficile.
The product is composed of a powder base (B) and 1 supplement (S).
MEDIUM PERFORMANCE:
1. Rapid detection compared to traditional media: big colonies (around 2 mm) of C. difficile after only 24 h of incubation in anaerobic atmosphere, contrary to traditional media requiring 48 h.
2. High sensitivity and specificity:C. difficile is detected by characteristic fluorescent colonies (under UV light at 365 nm) and the specimen’s flora largely inhibited.
3. Polyvalence: This medium can be used for clinical specimens as well as environmental samples.
TYPICAL APPEARANCE OF MICROORGANISMS:
C. difficile → colourless and fluorescent under UV light at 365 nm
Other bacteria → colourless, no fluorescent or inhibited
CHROMagar™ C.difficile is a new fluorogenic culture medium, extremely sensitive and selective, especially designed to simplify and speed up (24 h) the culture of C. difficile.
Clostridium difficile (C. difficile) is the leading cause of nosocomial infectious diarrhea in adults. These infections occur mostly in patients who have both medical care and antibiotic treatment and have become more frequent and more difficult to treat in the last years due to the emergence of highly toxigenic C. difficile strains. Although PCR has become the leading C. difficile detection technique, culture is essential for strain typing and antimicrobial susceptibility testing.